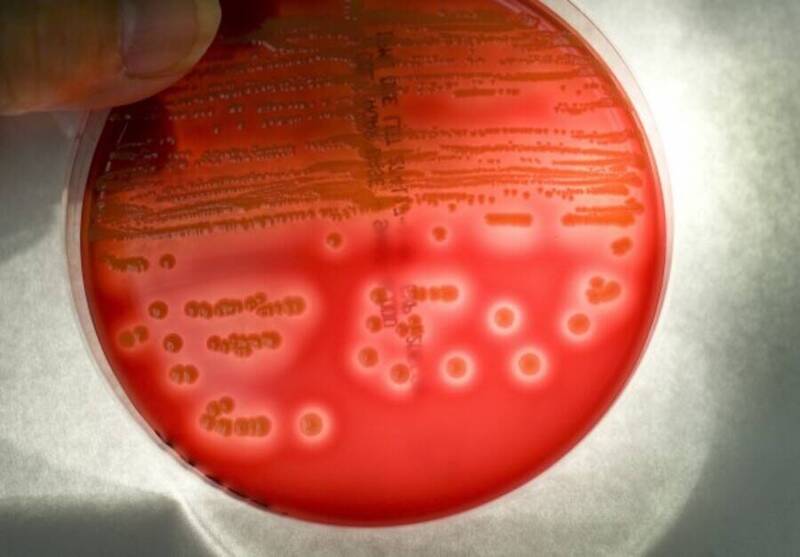

您即將進入之新聞內容 需滿18歲 方可瀏覽。
抗癌藥竟是細菌生的? 研究開發高效菌株 產量提高180%
〔編譯陳成導/綜合報導〕國際研究團隊開發出一種改造細菌菌株,使重要化療藥物阿黴素(Doxorubicin,台灣臨床上俗稱「小紅莓」)的產量在實驗中提高180%,有望改善這種抗癌藥的生產效率。這項突破可能降低製造成本,進而減輕全球癌症病患的經濟負擔。
這種重要抗癌藥製造效率長期受限,導致生產過程低效且昂貴。這不是因為藥物分子結構複雜,而是天然細菌的生產動力不足。新研究有望突破長達50年的製藥瓶頸。
據醫學新聞網站《Medical Xpress》報導,這項發表於《自然通訊》(Nature Communications)的研究,由芬蘭圖爾庫大學領導的團隊完成。研究人員成功破解了限制阿黴素產量的分子機制,不僅能提高藥物純度,更為抗癌藥物的全生物合成製程提供關鍵技術實證。
阿黴素自1970年代核准以來,一直是乳癌與淋巴瘤化療的基石,每年有超過100萬名病患接受治療。然而,製藥業長期依賴昂貴且複雜的半合成過程,主因是天然細菌生產效率極低。研究發現,產能瓶頸在於酵素反應速率過慢,且產出的藥物分子容易堵塞細菌的生物合成機制。
研究團隊利用X射線晶體繞射技術,首度觀測到生產機器中酵素運作的結構缺陷。為了解決此問題,團隊開發出一套「生物電力系統」(Redox partners)以提供穩定的電子流供能,並加入能與藥物結合的「分子海綿」蛋白質防止系統堵塞。在實驗環境下,新菌株的阿黴素產量比現行工業標準高出180%。
這項技術目前已由圖爾庫大學衍生的 Meta-Cells 公司(成立於2025年)啟動商業化應用,目標是將這套技術轉化為可量產的製程。研究人員指出,若能達成工業級產能,未來將有助於降低化療藥物的製造成本,並建立更穩定、環保的製藥供應鏈,減少對昂貴化學合成工序的依賴。
儘管實驗數據顯著,但團隊強調成果仍處於實驗室驗證階段。要將細菌工廠完全對接現有的藥品生產線,仍需針對工業級產量進行穩定性測試,並確保產出的藥物純度符合嚴格規範。這項發現為未來幾年內優化全球抗癌藥物生產,提供了關鍵的技術路徑。
發燒新聞